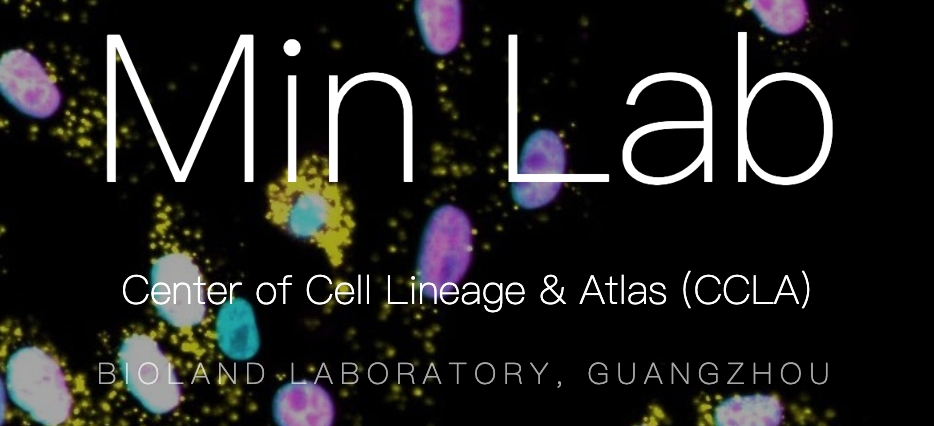

PaperWeekly 致力于推荐最棒的工作机会,精准地为其找到最佳求职者,做连接优质企业和优质人才的桥梁。如果你需要我们帮助你发布实习或全职岗位,请添加微信号「pwbot02」。
生物岛实验室成立于2017年12月22日,是广东省以培育创建国家实验室、打造国家实验室“预备队”为目标启动建设的首批省实验室之一,2019年6月获批为省级登记事业单位。
生物岛实验室面向国家和广东省重大战略需求,联合大湾区优势科研单位和众多国际顶尖科研力量,瞄准干细胞与再生医学理论与技术的前沿研究,布局再生医学前沿基础研究、临床创新研究、生物信息、生物安全研究以及高端生物医疗器械耗材研发五大科研方向,邀请了24位国内外院士加入,引入1200 余人、52个创新合作团队,形成了一支高水平研究队伍。生物岛实验室立足国际化、高起点,致力于建设重大科技基础设施和平台,打造再生医学与健康前沿研究基地、临床应用基地、成果转化及产业化基地和高水平人才基地,推动生物医药与健康产业高质量发展;同时,高度重视国际合作,积极搭建马普组织干细胞与再生医学研究中心等国际合作中心,深度参与大湾区建设,争取成为大湾区打造世界级科技创新中心的重要组成部分。
课题组简介
闵明玮研究员,2010年于四川大学取得学士学位,2014年于剑桥大学取得博士学位,随后在哈佛医学院和科罗拉多大学(Boulder)完成博士后训练,2020年受聘为生物岛实验室细胞命运与谱系研究中心研究员。前期工作主要专注于细胞增殖等基本的命运调控过程,未来将探索发育和抗压等生理病理过程中更广义的细胞命运决定。相关研究成果以第一或通迅作者发表在Science、PLoS Biology、Cell Reports、Molecular & Cellular Proteomics和 Molecular Biology of the Cell等国际知名期刊上。
实验室主要专注于细胞命运决定的研究。细胞是解读遗传信息的基本生命单位,通过与环境的相互作用,细胞和通过分裂产生的谱系把基因组里的信息转化成有生命的有机体。在构建有机体的发育过程中以及在多变的环境中维持生命稳态的过程中,细胞命运都在时间与空间层面上被严格地调控。我们将利用高通量活细胞成像和计算机辅助跟踪技术,获取细胞变化中时间和空间上的关键信息,通过在时空上精细可控的操作来探索系统组织中细胞谱系发生和变化的因果关系。我们的长期目标是建立可定量的理论模型来实现对细胞命运变化的解释与预测,为我们了解基本的生命活动过程 - 微观分子,物理和化学层面的信息如何导致宏观表型的变化 - 提供理论框架,同时基于这些理论框架对疾病提出有效可行的干预手段。我们诚邀对相关问题感兴趣,有生物学,数理,工程或计算机背景,热爱科学研究的青年才俊加入我们。更多信息,可点击链接或扫描二维码查看。
课题组主页:https://minlab.ac.cn/

副研究员/博士后
招聘人数:2人
岗位职责:
1. 参与研究课题设计,主导科研工作;
2. 指导及帮助实验室其他成员的工作,参与实验室内部以及与其它实验室的合作;
3. 通过撰写论文,作会议报告等方式交流自己的工作;
4. 独立或协助申请国内外的科研项目。
应聘条件:
1. 对生物学有浓厚的兴趣,有强烈的好奇心;
2. 拥有或即将获得生物、数理或工程博士学位,博士后获得博士学位不超过三年,年龄35岁以下,副研究员有至少两年博士后经历;
3. 能够主导推进课题;
4. 优秀的表达能力,良好的英语写作和交流能力;
5. 至少一项以下的专长/经验:1)分子、细胞、发育生物学,特别是细胞重编程及分化等命运改变模型,细胞通信,不对称分裂,压力反应;2)高通量测序建库与分析;3)计算机辅助图像处理方法的开发;光片显微镜。
科研助理
招聘人数:2人
岗位职责:
根据课题或项目需求,主导或协助完成科研工作。
应聘条件:
1. 拥有或即将获得生物、数理或工程等相关领域的硕士或学士学位;
2. 具备良好的沟通、表达能力和合作精神;
3. 较好的英语水平,能够无障碍理解英文文献;
4. 工作严谨细致,具备较强的责任心和执行力;
5. 有以下经验的可优先考虑:干细胞生物学;计算机辅助图像处理及深度学习在其中的应用;熟悉Matlab或Python。
实习生
招聘人数:2人
岗位职责:
协助课题组的图像处理方法开发和数据分析。
应聘条件:
1. 生物、数理或工程等相关专业本科生;
2. 熟悉Matlab或Python;
3. 较好的英语水平,能够理解英文文献;
4. 具备良好的沟通、表达能力和合作精神。
福利待遇
1. 提供具有国际竞争力的薪资待遇(年薪制,副研究员35-45w,博士后30-40w,科研助理8w-12w,实习生将给予一定补助),具体面议;
2. 提供一流的科研条件和训练环境:充足科研经费和齐全的科研设备,开放、平等、有活力、鼓励创新与合作的工作环境,根据个人的职业发展目标制定成长计划,提价专业和其它能力的训练;
3. 为高端人才组建科研支撑团队,根据工作能力和贡献发放相应补贴与绩效奖励;
4. 鼓励申报国家人才项目、广东省广州市开发区等各级人才项目,获取优厚人才补贴和福利,如广州市高层次人才可获100-500万人才补贴及其他丰厚福利待遇,可与薪酬叠加;
5. 高标准缴纳五险一金,带薪年假等全方位福利,协助解决住房、子女入学及健康保障等生活问题;
6. 其他福利待遇参照生物岛实验室相关规定执行。
应聘须知
1. 有意向者请将完整的个人简历,以及包含个人职业发展目标的cover letter等资料发送至邮箱:min_mingwei@grmh-gdl.cn,邮件主题:“申请岗位+姓名”。应聘者还需提供代表性成果和2-3名推荐人的联系方式;
2. 我单位承诺对应聘者提交的所有材料严格保密,将根据应聘者履历情况、研究成果及发展潜力等各方面进行初筛评估;初审通过后将以E-mail或电话形式通知面试的具体时间、地点及相关事项;
3. 初审未通过的应聘者不再另行通知,两个月内未收到回复的默认初审未通过;
4. 本招聘信息自发布之日起长期有效。
????
现在,在「知乎」也能找到我们了
进入知乎首页搜索「PaperWeekly」
点击「关注」订阅我们的专栏吧
关于PaperWeekly
PaperWeekly 是一个推荐、解读、讨论、报道人工智能前沿论文成果的学术平台。如果你研究或从事 AI 领域,欢迎在公众号后台点击「交流群」,小助手将把你带入 PaperWeekly 的交流群里。


























 被折叠的 条评论
为什么被折叠?
被折叠的 条评论
为什么被折叠?








